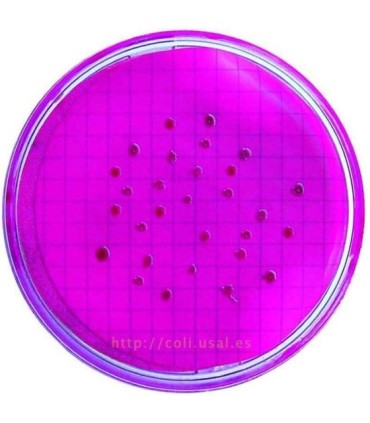
Coliformes Fecales En Agua

El grupo coliformes fecales se definen como bacilos gram negativos aerobios y anaerobios facultativos, no esporulados, que fermentan la lactosa formando ácido y gas dentro de 24 horas a 44,5 ± 0,2°C. En la actualidad se utiliza el grupo coliformes fecales, especialmente para calificar sanitariamente la calidad del agua.
El método utilizado se basa en la fermentación de la lactosa, el método de número mas probable (NMP), es un método estadístico, compuesto por una etapa presuntiva y una etapa confirmativa.
El ensayo consiste en sembrar diluciones seriadas de la muestra en medios líquidos, basándose en la combinación de tubos positivos se puede estimar el número de microorganismos presentes con el uso de la tabla estadística aportada por la referencia.